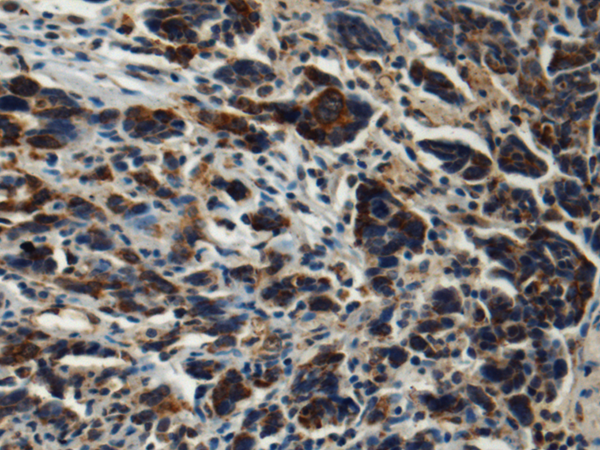
一抗

|
Background: |
Component of the MITRAC (mitochondrial translation regulation assembly intermediate of cytochrome c oxidase complex) complex, that regulates cytochrome c oxidase assembly. |
|
Applications: |
ELISA, IHC |
|
Name of antibody: |
CMC1 |
|
Immunogen: |
Fusion protein of human CMC1 |
|
Full name: |
C-X9-C motif containing 1 |
|
Synonyms: |
C3orf68 |
|
SwissProt: |
Q7Z7K0 |
|
ELISA Recommended dilution: |
5000-10000 |
|
IHC positive control: |
Human esophagus cancer and Human prostate cancer |
|
IHC Recommend dilution: |
150-300 |


 購(gòu)物車
購(gòu)物車 幫助
幫助
 021-54845833/15800441009
021-54845833/15800441009